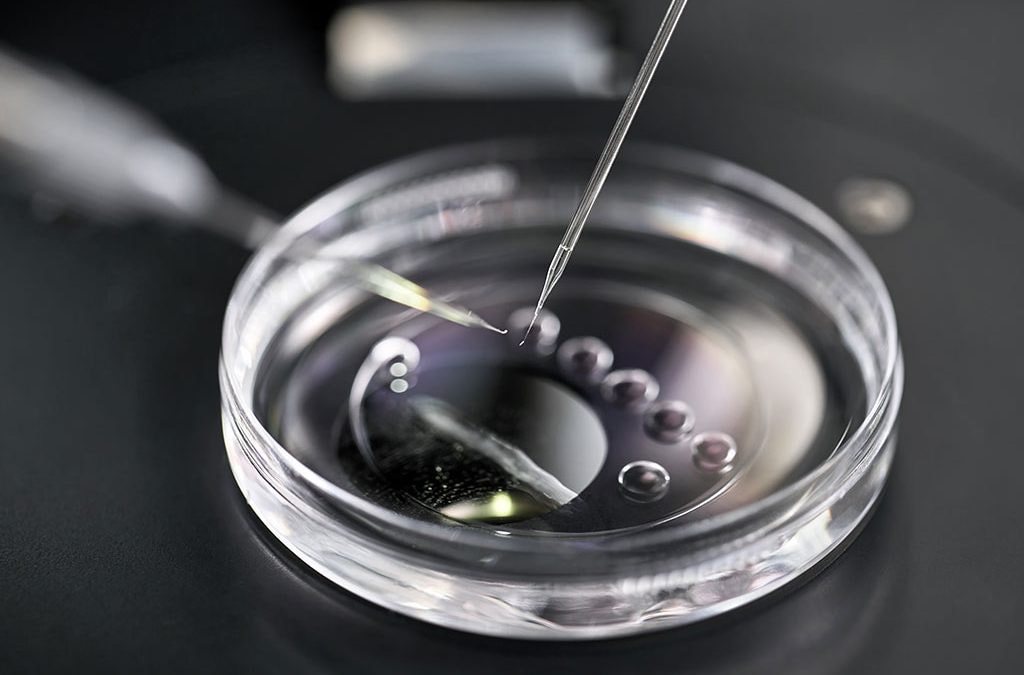
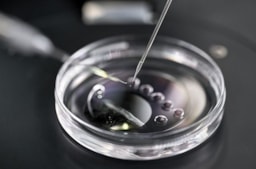

Overview
Amaal El-Maghraby is a paediatric and adult consultant in Endocrinology and Diabetes. He is a member of AACE. and AASD. Endocrinology is a medical realm that is concerned with the endocrine system, its ailments, and its secreted hormones. Endocrinologists deal with a plethora of psychological or behavioural activities, such as metabolism, growth, development, tissue function, sleep, digestion, respiration, excretion, mood, stress, lactation, movement, reproduction, and sensory perception triggered by hormones. Hormones are defined as chemical substances that influence the function of various organ systems in the body. Human organs are susceptible to numerous hormones, such as thyroid hormone, growth hormone, and insulin. See translation